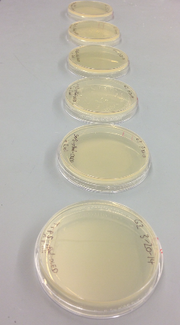

Uploads by Neeka Meshgin
From OpenWetWare
Jump to navigationJump to search
This special page shows all uploaded files.
| Date | Name | Thumbnail | Size | Description |
|---|---|---|---|---|
| 19:25, 25 April 2014 | Gel14-24.jpg (file) |  |
9 KB | |
| 17:23, 24 April 2014 | 4-17gel.jpg (file) |  |
76 KB | |
| 02:33, 15 April 2014 | 4-1platesG2.jpg (file) |  |
194 KB | |
| 02:18, 15 April 2014 | 3-20platesG2.jpg (file) | |
154 KB | |
| 02:14, 15 April 2014 | 3-20plates.jpg (file) |  |
832 KB | |
| 02:03, 15 April 2014 | 3-13gel.jpg (file) |  |
13 KB |